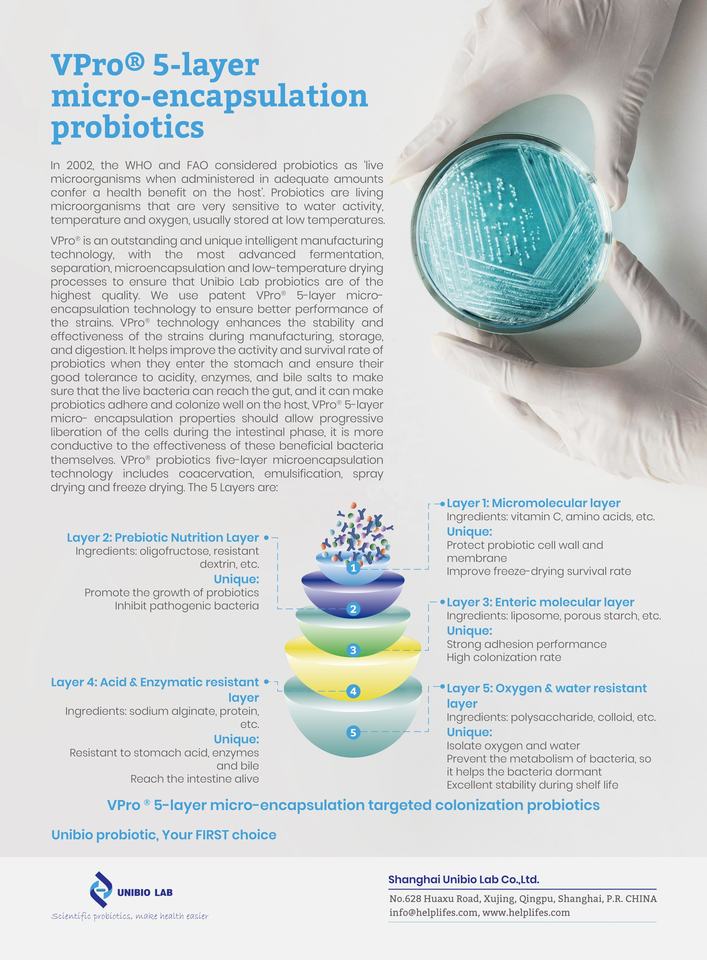

Custom Bifidobacterium Breve CCFM1025 Lactobacillus Gasseri CCFM1201 Mix Probiotic Capsules for Improve Menopausal Symptom
No reviews yet

Attributes
CapsulesDosage Form
sleep support, Immune Support, digestive health support, energy management, gut health support, nail growth, bone & joint supportproduct benefits
Improve Immunity, Providing Energy, Stimulate Insulin Secretion, Promote DigestionEffectiveness
Men, Women, Adult, Children, Middle-Aged and Elderly peopleApplicable People
NewbornNot Applicable People
24monthsShelf-Life
Main Ingredient:Bifidobacterium Breve CCFM1025, Lactobacillus Gasseri CCFM1201
Place of Origin:Shanghai, China
Bottle Capacity (pcs/bottle):30capsules/bottle
Type:Herbal supplements
Brand Name:Private Label
Model Number:HelpGut
Dose:Customerized
Product Specification:Customerized
Storage Method:Room temperature
Dietary Speciality:Gluten-Free
Studied Benefits Support:Improve Menopausal Symptom
Form:capsules
Appearance:30 cap/bottle or 60 caps /bottle
Potency:0.1Billion CFU/gram-300Billion CFU/gram
Specification:Alive/Tyndallized/Inactivated grade
Storage:Room temperature
Shelf Life:24 Months from Manufacturing Date
MOQ:5000 bottles/boxes
Package Size:customized
Certification:GMP/ISO/FSSC/Halal/Kosher/National High-tech Enterprise
Key attributes
Dosage Form
Capsules
product benefits
sleep support, Immune Support, digestive health support, energy management, gut health support, nail growth, bone & joint support
Effectiveness
Improve Immunity, Providing Energy, Stimulate Insulin Secretion, Promote Digestion
Applicable People
Men, Women, Adult, Children, Middle-Aged and Elderly people
Not Applicable People
Newborn
Shelf-Life
24months
Type
Herbal supplements
Main Ingredient
Bifidobacterium Breve CCFM1025, Lactobacillus Gasseri CCFM1201
Place of Origin
Shanghai, China
Bottle Capacity (pcs/bottle)
30capsules/bottle
Brand Name
Private Label
Model Number
HelpGut
Dose
Customerized
Product Specification
Customerized
Storage Method
Room temperature
Dietary Speciality
Gluten-Free
Studied Benefits Support
Improve Menopausal Symptom
Form
capsules
Appearance
30 cap/bottle or 60 caps /bottle
Potency
0.1Billion CFU/gram-300Billion CFU/gram
Specification
Alive/Tyndallized/Inactivated grade
Storage
Room temperature
Shelf Life
24 Months from Manufacturing Date
MOQ
5000 bottles/boxes
Package Size
customized
Certification
GMP/ISO/FSSC/Halal/Kosher/National High-tech Enterprise
Packaging and delivery
Selling Units
Single item
Single package size
30X18X21 cm
Single gross weight
2.500 kg
Lead time
1 - 99 boxes
$6
100 - 999 boxes
$580
>= 1000 boxes
$560
Variations
Select nowSupplier’s customization ability
Minor customization
Sample-based customization
Full customization
Shipping
Shipping fee and delivery date to be negotiated. Chat with supplier now for more details.
4 interest-free payments with
Alibaba.com order protection
Secure payments
Every payment you make on Alibaba.com is secured with strict SSL encryption and PCI DSS data protection protocols
Money-back protection
Claim a refund if your order doesn't ship, is missing, or arrives with product issues















